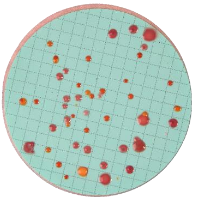
Nutrient Pad Sets-Standard TTC-NPS *

L-Tartaric Acid Standard Solution (10 g/L)
$356.68
MANUFACTURER: MEGAZYME
PRODUCT CODE: AS-TART
- Description
- Size Guide
- Specification
- Document
- Vendor Info
- More Products
Description
L-Tartaric Acid Standard Solution (10 g/L)
L-Tartaric Acid Standard Solution (10 g/L)
| Content: | 50 mL |
| Shipping Temperature: | Ambient |
| Storage Temperature: | 4oC |
| Physical Form: | Solution |
| Stability: | > 6 months under recommended storage conditions |
| CAS Number: | 87-69-4 |
| Synonyms: | 2,3-Dihydroxybutanedioic acid |
| Molecular Formula: | C4H6O6 |
| Molecular Weight: | 150.09 |
| Concentration: | 10 g/L |